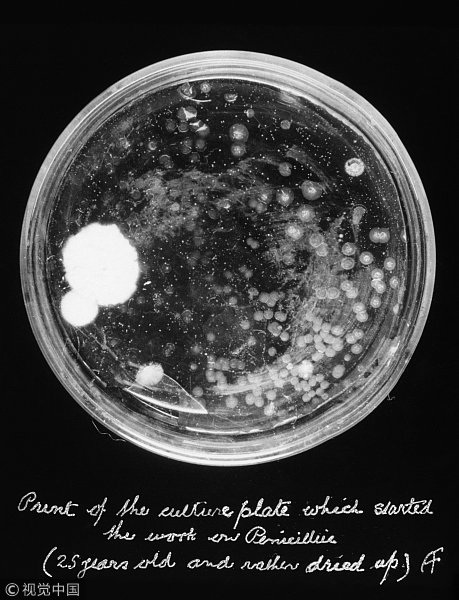
1

1928年,亚历山大·弗莱明在培养皿中发现青霉素
1928年9月3日的早晨,休假两周后,亚历山大·弗莱明(Alexander Fleming)刚刚回到伦敦圣玛丽医院(St. Mary’s Hospital)的实验室。他开始对有菌落的培养皿进行分类。这一过程中,弗莱明注意到一个培养皿中出现了一些不寻常的东西,由于失误,这个培养皿一直露天放置。
他看到蓝绿色的霉菌在生长,但是霉菌周围的区域却没有细菌。基于这一观察,弗莱明得出结论,这种霉菌分泌出了一种可以抑制或杀死微生物的物质,他后来将其称为青霉素。这个偶然的发现改变了现代医学史。青霉素将继续挽救数百万感染致命细菌的病人的生命。
然而,作为一名细菌学家,弗莱明知道进化不可避免,细菌最终会对抗生素产生抗药性。他的预测是正确的——1940年发现了第一个对青霉素产生耐药性的病原体。
从那时起,临床引进了许多抗菌药,天然的和半合成的都有。然而,使用几年后,对这些药物有耐药性的病原体也出现了。
最近出现的一种对碳青霉烯类产生耐药性的病原体是最令人担忧的,因为碳青霉烯类这种药是已知的针对对多种抗生素耐药的微生物的最后一道防线。这是全世界日益担忧的问题。根据美国疾病控制和预防中心(CDC)的数据,仅在美国,每年耐药细菌感染导致逾2.3万人死亡,除了直接医疗费用外,还会给美国造成至少200亿美元的损失。
不幸的是,目前正在开发的新型抗菌药物严重短缺,而目前正在使用的大多数抗菌药物都是对现有药物类别的修改。这对治疗严重感染的医生带来了巨大挑战,引发了人们对后抗生素时代到来的恐惧。
但是,最近科学家对宿主-病原体关系的理解取得了进展,对一种名为宿主导向疗法(HDT)的替代方法有了新的认识。这种疗法旨在增强宿主自身的免疫反应,而不是完全依赖抗菌药物。
用在宿主导向一些有前景的药物包括非传染性疾病的常用药物——维拉帕米(Verapamil)和二甲双胍(metformin),举例来讲,这些药物可以改善炎症并增加宿主对病原体的抗菌反应;细胞因子,包括白细胞介素在内的一组蛋白质,可诱导宿主促炎性细胞因子发出信号消灭病原体;还有维生素D3等营养品可以增强宿主的细胞防御能力。
宿主导向疗法还旨在通过减少或预防过度炎症反应来平衡宿主在感染部位的反应。炎症反应会损害内脏器官,严重时可致人死亡。宿主导向疗法是通过细胞疗法来实现的,在这种疗法中,将特定数量的骨髓细胞注射到宿主体内,减少和阻碍组织。
我目前的研究重点是了解细菌感染时宿主因子在宿主防御中的作用。研究还涉及探索宿主因子在炎症反应上怎样发挥微调作用。为此,我正在观察宿主因子对产生细胞因子的基因的影响。此外,由于铁在病原体的生长和炎症中发挥着重要作用,研究宿主因子对调节铁运输和代谢的基因的影响也在进行中。
充分了解这些因素如何有助于宿主防御和炎症控制对个体化治疗非常有帮助。个体化治疗时,患者的遗传特征可以指导对感染的治疗。我认为宿主因子基因的DNA中被称为多态性的细微差异,可以解释为什么有些人比其他人更容易感染病原体。通过识别人类的这些多态性,并将每个多态性与患者的病原体易感性水平联系起来,这样的话,研究可能会带来一种更有效的治疗细菌感染的方法。
作者: Zahidul Alam
品牌、内容合作请点这里:寻求合作 ››


 让您成为更懂趋势的人
让您成为更懂趋势的人
想看更多前瞻的文章?扫描右侧二维码,还可以获得以下福利:

下载APP

关注微信号


扫一扫下载APP
与资深行业研究员/经济学家互动交流让您成为更懂趋势的人
违法和不良信息举报电话:400-068-7188 举报邮箱:service@qianzhan.com 在线反馈/投诉 中国互联网联合辟谣平台
Copyright © 1998-2026 深圳前瞻资讯股份有限公司 All rights reserved. 粤ICP备11021828号-2 增值电信业务经营许可证:粤B2-20130734